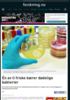
Én av ti friske bærer dødelige bakterier

Alle mediene redigeres i henhold til
redaktørplakaten og vær varsom-plakaten.
redaktørplakaten og vær varsom-plakaten.
forskning.no

forskning.no er en nettavis om norsk og internasjonal forskning.
forskning.no bringer nyheter, bakgrunnsstoff, faktainformasjon, blogger, debattstoff og multimedia om de fleste temaer som det forskes på.
forskning.no er Nordens største nettbaserte kanal for forskningsformidling.
forskning.no engasjerer og vekker nysgjerrighet, bidrar til ny innsikt og forståelse og til en kunnskapsbasert samfunnsdebatt.
forskning.no samarbeider med 81 norske forsknings- og utdanningsinstitusjoner, tillegg til utvalgte aviser og NRK Viten.
forskning.no måler lesertallene gjennom Google Analytics, som viser nær 818.000 besøk hvor ca 560.000 er unike.
forskning.no har ca 1,3 millioner sidevisninger pr måned.
Menn: 50% Kvinner: 50%
forskning.no bringer nyheter, bakgrunnsstoff, faktainformasjon, blogger, debattstoff og multimedia om de fleste temaer som det forskes på.
forskning.no er Nordens største nettbaserte kanal for forskningsformidling.
forskning.no engasjerer og vekker nysgjerrighet, bidrar til ny innsikt og forståelse og til en kunnskapsbasert samfunnsdebatt.
forskning.no samarbeider med 81 norske forsknings- og utdanningsinstitusjoner, tillegg til utvalgte aviser og NRK Viten.
forskning.no måler lesertallene gjennom Google Analytics, som viser nær 818.000 besøk hvor ca 560.000 er unike.
forskning.no har ca 1,3 millioner sidevisninger pr måned.
Menn: 50% Kvinner: 50%
forskning.no
Boks 5 Torshov
0412 OSLO
Tlf 22 80 98 90
Faks 22 80 98 99
Ansvarlig redaktør
Nina Kristiansen
22 80 98 90
414 55 513
nina@forskning.no
Annonseansvarlig
Arnt-Ove Drageset
92 44 58 46
ao@mediapilotene.no
Utgiver:
Foreningen for drift av forskning.no
Artikler fra mediet

forskning.no 14.06.2016

forskning.no 14.06.2016

forskning.no 14.06.2016

forskning.no 14.06.2016

forskning.no 14.06.2016
forskning.no 14.06.2016

forskning.no 14.06.2016

forskning.no 14.06.2016

forskning.no 14.06.2016

forskning.no 14.06.2016
Sider
Nyhetsbrev
Lag ditt eget nyhetsbrev:




































































































